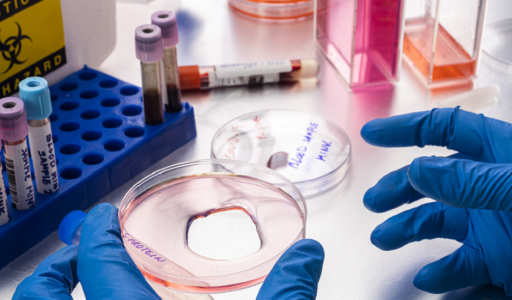
First slide

مؤشر حيوي جديد لمحاربة ارتفاع ضغط الدم وداء السكري
تكشف البروتينات المنتشرة في الدم عن مؤشرات دقيقة لما يحدث داخل الجسم، بدءا من آليات معالجة الطاقة ووصولا إلى تطور الأمراض.
وأظهرت النتائج وجود تباين واضح في مستويات هذه البروتينات تبعا للعمر والجنس والخلفية الوراثية ونمط الحياة واستخدام الأدوية.
وتكشف النتائج على وجه الخصوص عن دور لافت لبروتين ACE2، إذ ارتفعت مستوياته لدى المصابين بارتفاع ضغط الدم أو داء السكري، وهما من أبرز عوامل خطر الإصابة بأمراض القلب. وكان هذا الارتفاع أكثر وضوحا لدى النساء، كما ارتبط بتغيرات جينية متعلقة بداء السكري.
وباستخدام تحليل "التوزيع العشوائي المندلي ثنائي العينة"، توصل الباحثون إلى أن زيادة مستويات ACE2 قد تمثل آلية وقائية طبيعية ضد ارتفاع ضغط الدم وداء السكري من النوع الثاني.
ويعمل هذا البروتين على تفكيك الأنجيوتنسين II، الذي يسبب تضيق الأوعية الدموية، واستبداله بمركبات تساعد على إرخائها، ما يشير إلى أن ارتفاع مستوياته لدى مرضى الضغط قد يكون استجابة تعويضية لحماية الأوعية الدموية.
وتكتسب هذه النتائج أهمية سريرية كبيرة في ظل الانتشار الواسع لارتفاع ضغط الدم وداء السكري، إذ تفتح المجال لاعتماد بروتين ACE2 كمؤشر حيوي جديد قد يساعد في تحسين التشخيص والمتابعة والعلاج، فضلا عن فهم أعمق للآليات الوقائية في الجهاز القلبي الوعائي.
وتثير الدراسة تساؤلات مهمة حول العلاجات الحالية، ولا سيما مثبطات الإنزيم المحوّل للأنجيوتنسين (ACE)، المستخدمة على نطاق واسع لعلاج ارتفاع ضغط الدم. وتشير النتائج إلى أن التوازن بين بروتيني ACE2 وACE1 قد يؤثر في فاعلية هذه الأدوية، ما يمهّد الطريق أمام علاجات أكثر تخصيصا وفق مستويات ACE2 لدى المرضى.
وتفتح النتائج أيضا آفاقا بحثية لدراسة إمكان تعزيز نشاط ACE2 أو محاكاة تأثيراته لتحسين علاج ضغط الدم والسكري. كما تدعم نتائج سابقة أظهرت أن دواء الميتفورمين، المستخدم لعلاج السكري، يزيد من التعبير عن هذا البروتين كجزء من آلية عمله.
نشرت الدراسة في مجلة "Circulation: الجينوم والطب الدقيق".